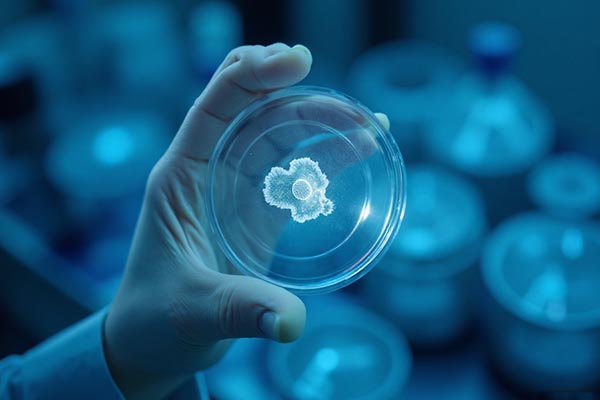
La des-extinción ya está aquí. El regreso del mamut lanudo plantea dudas éticas sobre jugar a ser Dios. Conoce los argumentos a favor, en contra y la ciencia real detrás de este hito genético.

El regreso del mamut lanudo es inminente
Mamuts vivos en 4 años: ¿Milagro de la ciencia o error ético?
Olvídate de la ciencia ficción y guarda las palomitas, porque lo que estamos viviendo en este 2026 supera cualquier guion de Hollywood. Si creciste pensando que ver un mamut era algo imposible, te tengo noticias: estamos a nada de presenciarlo. El regreso del mamut lanudo ya no es un sueño guajiro de científicos locos; es una realidad que tiene fecha en el calendario y que, sinceramente, nos pone la piel chinita a todos.
Entiendo perfectamente esa mezcla de emoción y miedo que sientes. Por un lado, ¡qué increíble ver a un gigante de la Era de Hielo! Pero por otro, resuena esa vocecita interna preguntando: “¿De verdad deberíamos estar haciendo esto?”. En este artículo no solo te voy a contar el chisme completo de cómo lo van a lograr en menos de cuatro años, sino que vamos a desmenuzar el debate ético y ambiental que tiene al mundo científico agarrado del chongo. Prepárate, porque la historia natural está a punto de reescribirse.
¿Cómo es posible revivir a un gigante extinto hoy?
A ver, vamos a aclarar algo importantísimo para que no te cuenteen: no es como en las películas donde sacan sangre de un mosquito en ámbar. Eso no funciona así. El ADN se degrada con el tiempo, y después de 4,000 años (que es cuando murió el último mamut en la Isla de Wrangel), lo que queda son rompecabezas incompletos.
La empresa que está liderando esta locura es Colossal Biosciences, y no están “clonando” un mamut en el sentido estricto. Lo que están haciendo es un trabajo de “corte y confección” genética de altísimo nivel. Utilizan una herramienta llamada CRISPR-Cas9, que son como unas tijeras moleculares ultra precisas.
El papel clave del elefante asiático
Aquí es donde entra el pariente vivo más cercano: el elefante asiático. Comparten el 99.6% de su ADN con el mamut lanudo. Lo que los científicos, liderados por el genio de la genética George Church, están haciendo es tomar células de elefante asiático y “editarlas” para insertar los genes del mamut que le daban sus características únicas:
- El pelo largo y grueso para aguantar el frío.
- Las capas extra de grasa subcutánea.
- Orejas pequeñas para evitar la pérdida de calor.
- Sangre adaptada para fluir en temperaturas bajo cero.
Básicamente, están creando un híbrido, un “elefante funcionalmente mamut”. No es un mamut puro, es un animal diseñado para cumplir la misma función ecológica que su ancestro.
Si quieres clavarte más en la ciencia dura detrás de la edición genética, te recomiendo echarle un ojo a los estudios publicados por la revista Nature, donde se detalla cómo el CRISPR ha revolucionado la biología moderna.
El argumento a favor: ¿Salvar el mundo o jugar a ser Dios?
Seguramente te preguntas: “¿Para qué gastar millones de dólares en esto cuando tenemos tantos problemas?”. Y es una pregunta súper válida. Pero la respuesta de los defensores del proyecto, como el empresario Ben Lamm (cofundador de Colossal), es que no se trata de abrir un zoológico turístico.
El objetivo real es combatir el cambio climático. Suena raro, ¿no? Déjame explicarte la teoría del “Parque Pleistoceno”.
La ingeniería del ecosistema ártico
Hace miles de años, cuando los mamuts pisaban la tundra, su comportamiento mantenía el suelo congelado. Al pisotear la nieve, compactaban el hielo y permitían que el frío penetrara más profundo en la tierra, protegiendo el permafrost.
Hoy, sin esos grandes herbívoros, la nieve actúa como un abrigo que calienta la tierra, derritiendo el permafrost y liberando toneladas de metano y carbono atrapados. La idea es que, al reintroducir manadas de estos “mamuts”, ellos:
- Derribarán árboles pequeños, permitiendo que crezca pasto que refleja la luz solar.
- Compactarán la nieve para mantener el suelo frío.
- Restaurarán la estepa del mamut, un ecosistema altamente eficiente en la captura de carbono.
“No estamos trayendo de vuelta al mamut solo por curiosidad. Estamos restaurando un ingeniero de ecosistemas vital para la salud de nuestro planeta. Es una herramienta de conservación activa.” — George Church, genetista de Harvard.
La controversia ética: ¿Hemos ido demasiado lejos?
Aquí es donde se pone color de hormiga. No todos están aplaudiendo. De hecho, hay una comunidad científica enorme que está muy preocupada y hasta enojada con esta iniciativa. Y tienen puntos muy fuertes.
El sufrimiento de los elefantes modernos
Para que nazca un mamut, necesitas una madre. Y aquí el plan es usar elefantes asiáticos como madres subrogadas (o vientres de alquiler). El problema es que el elefante asiático ya está en peligro de extinción. Someter a estas hembras a procedimientos experimentales, embarazos de riesgo y el estrés de gestar una especie diferente podría considerarse maltrato animal.
Expertos de organizaciones como el World Wildlife Fund (WWF) han señalado que los recursos millonarios destinados a la des-extinción deberían usarse para salvar a las especies que todavía tenemos y que se están muriendo hoy, como el rinoceronte de Java o la vaquita marina aquí en México.
¿Un animal sin manada?
Los elefantes son seres extremadamente sociales e inteligentes. Aprenden de sus mayores. Si nace el primer bebé mamut en 2029 o 2030… ¿quién le va a enseñar a ser un mamut? No tiene madre de su especie, no tiene manada, no tiene cultura. Existe el riesgo de traer al mundo a criaturas solitarias y psicológicamente traumadas.
ALERTA Y PRECAUCIONES ECOLÓGICAS
⚠ El riesgo de las especies invasoras
Hay una regla de oro en la biología: no introduzcas cosas donde no pertenecen. Aunque el mamut vivió ahí hace miles de años, el ecosistema ha cambiado. Reintroducir una megafauna podría tener efectos impredecibles.
¿Qué pasa si estos nuevos mamuts compiten por comida con los caribúes o los renos que ya viven ahí y que son sustento de comunidades indígenas? ¿Qué pasa si traen virus inactivos o si, al ser animales de laboratorio, introducen patógenos nuevos al Ártico? La bioseguridad es un tema que, según críticos como la ecóloga Torill Kulø, no se está tomando con la suficiente seriedad. Jugar con la naturaleza siempre tiene consecuencias imprevistas.
La tecnología detrás del milagro: CRISPR y úteros artificiales
Para evitar el dilema de usar elefantes vivos, Colossal Biosciences también está invirtiendo en el desarrollo de úteros artificiales. Imagínate bolsas gigantes llenas de líquido amniótico sintético donde el feto se desarrolla fuera de un cuerpo. Suena a “Matrix”, pero es la única forma ética viable de escalar esto a nivel de manadas.
Actualmente, laboratorios vinculados a la Escuela de Medicina de Harvard están perfeccionando estas técnicas. Si logran criar mamuts en úteros artificiales, no solo resuelven el problema ético, sino que revolucionarían la medicina reproductiva para todas las especies, incluidos los humanos.
Cronología estimada del proyecto
- 2021-2024: Recaudación de fondos y secuenciación completa del genoma (Ya completado).
- 2025-2026: Creación exitosa de embriones viables con edición CRISPR (Estamos aquí).
- 2027-2028: Implantación en madres subrogadas o úteros artificiales experimentales.
- 2029-2030: Nacimiento de los primeros vallenatos (crías) de mamut lanudo.
Un ejemplo concreto: El Parque Pleistoceno en Siberia
Para que veas que esto no es pura teoría, ya existe el lugar a donde irían estos animales. Se llama el Parque Pleistoceno, ubicado en Chersky, Siberia. Fundado por el científico ruso Sergey Zimov, este lugar lleva años experimentando con bisontes, caballos y bueyes almizcleros para recrear la estepa antigua.
Zimov ha demostrado que, efectivamente, la presencia de animales baja la temperatura del suelo. Pero le falta la pieza clave: el “tanque” de la naturaleza, el mamut, capaz de tirar árboles grandes. Si el proyecto de Colossal tiene éxito, este rincón de Rusia será el primer hogar de los nuevos gigantes.
Puedes leer más sobre los esfuerzos de conservación actuales y la lista roja de especies en la Unión Internacional para la Conservación de la Naturaleza (UICN), para entender qué está en juego.
Preguntas Frecuentes sobre el Regreso del Mamut
¿Serán agresivos los nuevos mamuts?
No lo sabemos con certeza. Al ser híbridos con elefante asiático, es probable que hereden su temperamento, que puede ser dócil pero peligroso si se sienten amenazados. Al no tener padres mamuts que les enseñen conducta, su comportamiento es una incógnita.
¿Podremos comer carne de mamut?
Técnicamente, una empresa australiana ya creó una albóndiga de carne de mamut cultivada en laboratorio en 2023 usando su secuencia de ADN. Sin embargo, los mamuts vivos de Colossal no están destinados al consumo, sino a la ingeniería ecológica.
¿Van a clonar también dinosaurios?
No. El ADN de los dinosaurios (65 millones de años) ha desaparecido por completo. El límite teórico para recuperar ADN legible es de aproximadamente un millón de años. Los mamuts son “recientes” (4,000 años), por eso es posible.
¿Qué clima necesitan para sobrevivir?
Están diseñados para el Ártico, soportando temperaturas de hasta -40°C. Sin embargo, como híbridos, podrían tener cierta tolerancia a climas más templados, pero sufrirían mucho en zonas tropicales o desérticas.
El futuro ya nos alcanzó
Estamos parados en un umbral histórico. En menos de cuatro años, es muy probable que prendamos las noticias y veamos la primera imagen de una cría peluda con trompa, respirando el aire de nuestro siglo. El regreso del mamut lanudo es un testamento del ingenio humano, de nuestra capacidad para doblar las reglas de la biología a nuestro antojo.
Pero también es un espejo. ¿Estamos trayéndolos de vuelta por arrogancia o por una genuina necesidad de sanar el planeta? Quizás ambas. Lo único seguro es que, una vez que ese primer mamut abra los ojos, ya no habrá vuelta atrás. La caja de Pandora de la des-extinción se habrá abierto para siempre. Y tú y yo estaremos aquí para verlo.
¿Te gustaría ver un mamut en vivo? Mantente atento, porque el debate sobre si deberían existir zoológicos para estos animales será la próxima gran batalla cultural, y tu opinión contará más que nunca. Si quieres saber más sobre regulaciones biológicas, visita el sitio de la FDA de EE. UU., quienes seguramente tendrán que regular estos organismos.
https://www.akronoticias.com/202601/el-regreso-del-mamut-lanudo-es-inminente.htmhttps://www.akronoticias.com/wp-content/uploads/2026/01/El-regreso-del-mamut-lanudo.jpghttps://www.akronoticias.com/wp-content/uploads/2026/01/El-regreso-del-mamut-lanudo-150x150.jpgA fondoMamuts vivos en 4 años: ¿Milagro de la ciencia o error ético? Olvídate de la ciencia ficción y guarda las palomitas, porque lo que estamos viviendo en este 2026 supera cualquier guion de Hollywood. Si creciste pensando que ver un mamut era algo imposible, te tengo noticias: estamos a nada...Armando NevárezArmando Neváreza_nevarez_a@yahoo.comAdministratorCon una sólida trayectoria de más de 25 años en el periodismo, Armando Nevárez se ha consolidado como una voz autorizada en los medios de comunicación a nivel binacional. Su carrera, forjada en la búsqueda de la verdad y la excelencia informativa, abarca colaboraciones destacadas en México para medios de renombre como El Diario de Juárez, Akronoticias y Metro Noticias de Chihuahua. En Estados Unidos, ha ampliado su influencia colaborando en Prensa Latina, Metro Noticias Las Vegas, entre otros. Más allá de la noticia, Nevárez ha canalizado su vasta experiencia en la observación humana hacia su faceta como escritor. Es autor de múltiples obras enfocadas en el desarrollo personal, el trabajo en equipo y el liderazgo. Su escritura combina la claridad y objetividad del periodista con la profundidad necesaria para inspirar el crecimiento humano, ofreciendo herramientas prácticas para aquellos que buscan transformar su entorno y alcanzar su máximo potencial.Akronoticias